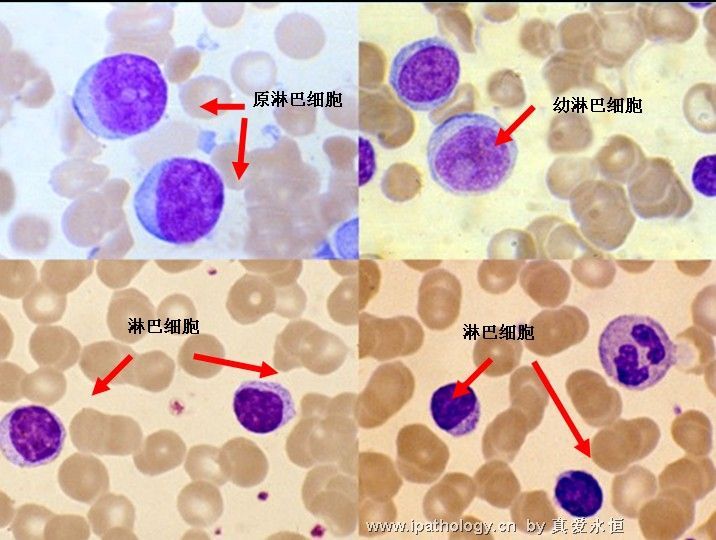
急性淋巴细胞白血病

急性淋巴细胞白血病

急性淋巴细胞白血病
图片尺寸1280x950
急性淋巴细胞白血病 l1
图片尺寸864x629
急性淋巴细胞白血病,原因,体征和症状,诊断和治疗你了解多少?
图片尺寸640x360
急性淋巴细胞白血病
图片尺寸347x395
白血病 #抗白小勇士 #抗白之路 #急性淋巴细胞白血病 收 - 抖音
图片尺寸1440x1920
急性淋巴细胞白血病
图片尺寸716x540
ph阳性急性淋巴细胞白血病患者的快速诊断与治疗1例
图片尺寸660x716
急性淋巴细胞白血病l3图谱
图片尺寸1280x960
急性淋巴细胞白血病
图片尺寸1280x950
恐艾 艾滋病暴露阻断药物的金字塔——必妥维
图片尺寸660x441
白血病主要分为急性淋巴细胞白血病,急性髓细胞白血病,慢性淋巴细胞
图片尺寸1080x882
急性感染期二,艾滋病病人的早期症状有什么所以当您的身体出现淋巴结
图片尺寸722x538
急性淋巴细胞白血病l3图谱
图片尺寸2868x2868
什么是急性淋巴细胞白血病
图片尺寸1080x1440
外周血涂片#淋巴细胞白血病
图片尺寸610x998
急性白血病是一种特殊的疾病,它可以进行治疗,治疗方法简单有效
图片尺寸640x486
急性淋巴细胞白血病
图片尺寸1280x950
急性淋巴细胞白血病
图片尺寸1280x950
急性淋巴细胞白血病
图片尺寸1080x809
急性白血病m2
图片尺寸800x600